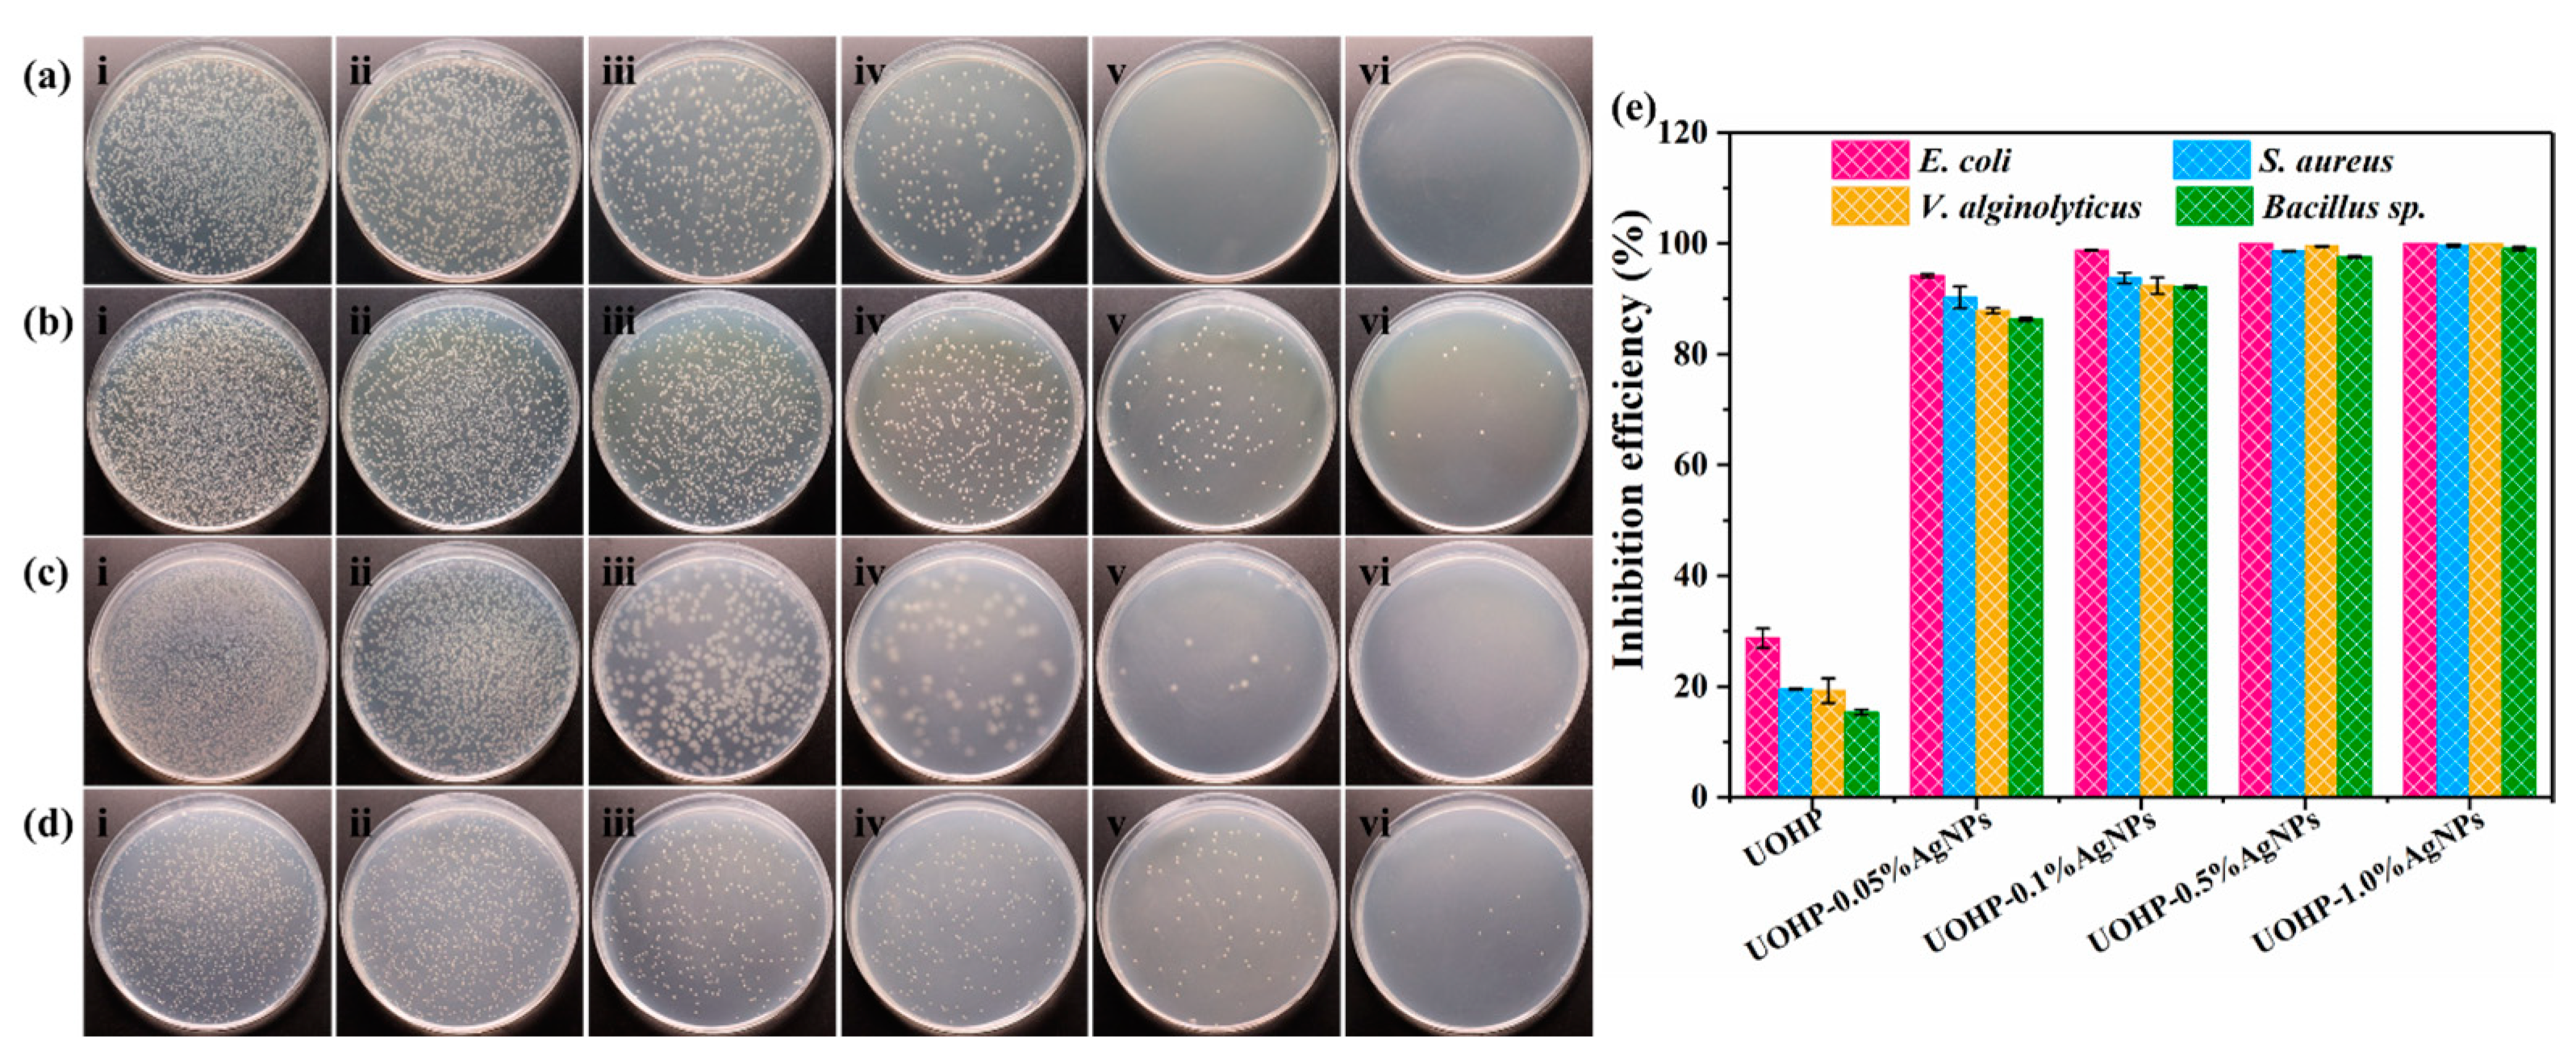
Polymers 16 01167 g008

In Situ Reduction of Silver Nanoparticles/Urushiol-Based Polybenzoxazine Composite Coatings with Enhanced Antimicrobial and Antifouling Performances
Abstract
1. Introduction
2. Materials and Methods
2.1. Materials
2.2. Synthesis of Urushiol-Based Benzoxazine Monomers (UB)
2.3. Preparation of Silver Nanoparticles by In Situ Reduction of Urushiol-Based Benzoxazines
2.4. Fabrication of Silver Nanoparticles by In Situ Reduction of Urushiol-Based Benzoxazines Polymer Coatings
2.5. Characterizations
2.6. Antibacterial Performance Assessments
2.7. Algal Inhibition Assessments
3. Results and Discussion
3.1. Synthesis and Characterization of UOB/AgNP Composites
3.2. Characterization of UOHP/AgNP Composite Coatings
3.3. Thermal Stability of UOHP/AgNP Composite Coatings
3.4. Surface Properties of UOHP/AgNP Composite Coatings
3.5. Fouling-Resistant Assays of UOHP/AgNP Composite Coatings
4. Conclusions
Author Contributions
Funding
Institutional Review Board Statement
Data Availability Statement
Conflicts of Interest
References
- Qiu, H.; Feng, K.; Gapeeva, A.; Meurisch, K.; Kaps, S.; Li, X.; Yu, L.; Mishra, Y.K.; Adelung, R.; Baum, M. Functional polymer materials for modern marine biofouling control. Prog. Polym. Sci. 2022, 127, 101516. [Google Scholar] [CrossRef]
- Bannister, J.; Sievers, M.; Bush, F.; Bloecher, N. Biofouling in marine aquaculture: A review of recent research and developments. Biofouling 2019, 35, 631–648. [Google Scholar] [CrossRef] [PubMed]
- Yang, W.J.; Neoh, K.-G.; Kang, E.-T.; Teo, S.L.-M.; Rittschof, D. Polymer brush coatings for combating marine biofouling. Prog. Polym. Sci. 2014, 39, 1017–1042. [Google Scholar] [CrossRef]
- Cao, P.; He, X.; Xiao, J.; Yuan, C.; Bai, X. Covalent bonding of AgNPs to 304 stainless steel by reduction in situ for antifouling applications. Appl. Surf. Sci. 2018, 452, 201–209. [Google Scholar] [CrossRef]
- Li, M.-y.; Zhang, B.-x.; Chen, L.-l.; Kong, J.-j.; Wang, Y.-f.; Ba, M. Spontaneous directed leaching of slippery lubricant in self-stratified marine antifouling coatings for nonporous surfaces. Prog. Org. Coat. 2023, 184, 107858. [Google Scholar] [CrossRef]
- Hu, P.; Xie, Q.; Ma, C.; Zhang, G. Silicone-based fouling-release coatings for marine antifouling. Langmuir 2020, 36, 2170–2183. [Google Scholar] [CrossRef] [PubMed]
- Michailidis, M.; Gutner-Hoch, E.; Wengier, R.; Onderwater, R.; D’Sa, R.A.; Benayahu, Y.; Semenov, A.; Vinokurov, V.; Shchukin, D.G. Highly effective functionalized coatings with antibacterial and antifouling properties. ACS Sustain. Chem. Eng. 2020, 8, 8928–8937. [Google Scholar] [CrossRef]
- Seo, E.; Lee, J.W.; Lee, D.; Seong, M.R.; Kim, G.H.; Hwang, D.S.; Lee, S.J. Eco-friendly erucamide-polydimethylsiloxane coatings for marine anti-biofouling. Colloids Surf. B 2021, 207, 112003. [Google Scholar] [CrossRef] [PubMed]
- Peres, R.S.; Armelin, E.; Alemán, C.; Ferreira, C.A. Modified tannin extracted from black wattle tree as an environmentally friendly antifouling pigment. Ind. Crop. Prod. 2015, 65, 506–514. [Google Scholar] [CrossRef]
- Li, P.; Cai, C.; Long, Y.; Zhu, T.; Dong, H.; Zhu, C.; Zhao, N.; Xu, J. Cu2O-clay composites with sub-micrometer-sized Cu2O particles for marine antifouling paints. J. Coat. Technol. Res. 2018, 16, 25–30. [Google Scholar] [CrossRef]
- Bressy, C.; Briand, J.F.; Lafond, S.; Davy, R.; Mazeas, F.; Tanguy, B.; Martin, C.; Horatius, L.; Anton, C.; Quiniou, F.; et al. What governs marine fouling assemblages on chemically-active antifouling coatings? Prog. Org. Coat. 2022, 164, 106701. [Google Scholar] [CrossRef]
- Omae, M. General aspects of tin-free antifouling paints. Chem. Rev. 2003, 103, 3431–3448. [Google Scholar] [CrossRef] [PubMed]
- Wang, W.; Li, Y.; Wang, W.; Gao, B.; Wang, Z. Palygorskite/silver nanoparticles incorporated polyamide thin film nanocomposite membranes with enhanced water permeating, antifouling and antimicrobial performance. Chemosphere 2019, 236, 124396. [Google Scholar] [CrossRef] [PubMed]
- Martins, I.M.; Sampaio, A.G.; Lima, G.M.G.; Oliveira e Campos, M.A.C.; Rodgher, S.; Rodrigues-Siqueli, A.C.; Baldan, M.R.; Marcuzzo, J.S.; Koga-Ito, C.Y. Application of textile (PAN-based) activated carbon fibers decorated with silver nanoparticles in water treatment. Front. Env. Sci. 2023, 10, 1100583. [Google Scholar] [CrossRef]
- Pasparakis, G. Recent developments in the use of gold and silver nanoparticles in biomedicine. WIRES Nanomed. Nanobi. 2022, 14, e1817. [Google Scholar] [CrossRef] [PubMed]
- Gherasim, O.; Puiu, R.A.; Birca, A.C.; Burdusel, A.C.; Grumezescu, A.M. An Updated Review on Silver Nanoparticles in Biomedicine. Nanomaterials 2020, 10, 2381. [Google Scholar] [CrossRef] [PubMed]
- Krasniewska, K.; Galus, S.; Gniewosz, M. Biopolymers-Based Materials Containing Silver Nanoparticles as Active Packaging for Food Applications-A Review. Int. J. Mol. Sci. 2020, 21, 698. [Google Scholar] [CrossRef] [PubMed]
- Gallocchio, F.; Cibin, V.; Biancotto, G.; Roccato, A.; Muzzolon, O.; Carmen, L.; Simone, B.; Manodori, L.; Fabrizi, A.; Patuzzi, I.; et al. Testing nano-silver food packaging to evaluate silver migration and food spoilage bacteria on chicken meat. Food Addit. Contam. Part A 2016, 33, 1063–1071. [Google Scholar] [CrossRef] [PubMed]
- Bryaskova, R.; Georgieva, N.; Andreeva, T.; Tzoneva, R. Cell adhesive behavior of PVA-based hybrid materials with silver nanoparticles. Surf. Coat. Technol. 2013, 235, 186–191. [Google Scholar] [CrossRef]
- Lu, G.; Tian, S.; Li, J.; Xu, Y.; Liu, S.; Pu, J. Fabrication of bio-based amphiphilic hydrogel coating with excellent antifouling and mechanical properties. Chem. Eng. J. 2021, 409, 128134. [Google Scholar] [CrossRef]
- Barua, S.; Konwarh, R.; Bhattacharya, S.S.; Das, P.; Devi, K.S.; Maiti, T.K.; Mandal, M.; Karak, N. Non-hazardous anticancerous and antibacterial colloidal ‘green’ silver nanoparticles. Colloid. Surf. B 2013, 105, 37–42. [Google Scholar] [CrossRef] [PubMed]
- Chandraker, S.K.; Kumar, R. Biogenic biocompatible silver nanoparticles: A promising antibacterial agent. Biotechnol. Genet. 2022, 1–35. [Google Scholar] [CrossRef] [PubMed]
- Xie, Q.; Pan, J.; Ma, C.; Zhang, G. Dynamic surface antifouling: Mechanism and systems. Soft Matter 2019, 15, 1087–1107. [Google Scholar] [CrossRef] [PubMed]
- Yang, H.; Chang, H.; Zhang, Q.; Song, Y.; Jiang, L.; Jiang, Q.; Xue, X.; Huang, W.; Ma, C.; Jiang, B. Highly branched copolymers with degradable bridges for antifouling coatings. ACS Appl. Mater. Interfaces 2020, 12, 16849–16855. [Google Scholar] [CrossRef] [PubMed]
- Xie, Q.; Xie, Q.; Pan, J.; Ma, C.; Zhang, G. Biodegradable Polymer with Hydrolysis-Induced Zwitterions for Antibiofouling. ACS Appl. Mater. Interfaces 2018, 10, 11213–11220. [Google Scholar] [CrossRef] [PubMed]
- Zhang, P.; Lin, L.; Zang, D.; Guo, X.; Liu, M. Designing Bioinspired Anti-Biofouling Surfaces based on a Superwettability Strategy. Small 2017, 13, 1503334. [Google Scholar] [CrossRef]
- Dundar Arisoy, F.; Kolewe, K.W.; Homyak, B.; Kurtz, I.S.; Schiffman, J.D.; Watkins, J.J. Bioinspired Photocatalytic Shark-Skin Surfaces with Antibacterial and Antifouling Activity via Nanoimprint Lithography. ACS Appl. Mater. Interfaces 2018, 10, 20055–20063. [Google Scholar] [CrossRef]
- Xu, X.; Chen, R.; Sun, G.; Yu, J.; Liu, Q.; Liu, J.; Lin, C.; Liu, P.; Wang, J. A facile hydrophilic modification strategy initiated by flame treatment of silicone coatings for marine antifouling application. Appl. Surf. Sci. 2022, 580, 152177. [Google Scholar] [CrossRef]
- Yamamoto, S.; Kitahata, S.; Shimomura, A.; Tokuda, K.; Nishino, T.; Maruyama, T. Surfactant-induced polymer segregation to produce antifouling surfaces via dip-coating with an amphiphilic polymer. Langmuir 2015, 31, 125–131. [Google Scholar] [CrossRef]
- Zhang, H.; Liang, T.; Liu, Y.; Misra, R.D.K.; Zhao, Y. Low-surface-free-energy GO/FSiAC coating with self-healing function for anticorrosion and antifouling applications. Surf. Coat. Technol. 2021, 425, 127690. [Google Scholar] [CrossRef]
- Cao, Z.; Cao, P. Research Progress on Low-Surface-Energy Antifouling Coatings for Ship Hulls: A Review. Biomimetics 2023, 8, 502. [Google Scholar] [CrossRef] [PubMed]
- Guo, H.; Song, L.; Hu, J.; Lin, T.; Li, X.; Yu, H.; Cheng, D.; Hou, Y.; Zhan, X.; Zhang, Q. Enhanced antifouling strategy with a strong synergistic effect of fluorescent antifouling and contact bacteriostasis using 7-amino-4-methylcoumarin. Chem. Eng. J. 2021, 420, 127676. [Google Scholar] [CrossRef]
- Tong, Z.; Guo, H.; Di, Z.; Sheng, Y.; Song, L.; Hu, J.; Gao, X.; Hou, Y.; Zhan, X.; Zhang, Q. Squid inspired elastomer marine coating with efficient antifouling strategies: Hydrophilized defensive surface and lower modulus. Colloids Surf. B 2022, 213, 112392. [Google Scholar] [CrossRef] [PubMed]
- Chen, J.; Jian, R.; Yang, K.; Bai, W.; Huang, C.; Lin, Y.; Zheng, B.; Wei, F.; Lin, Q.; Xu, Y. Urushiol-based benzoxazine copper polymer with low surface energy, strong substrate adhesion and antibacterial for marine antifouling application. J. Clean. Prod. 2021, 318, 128527. [Google Scholar] [CrossRef]
- Chen, J.; Bai, W.; Jian, R.; Lin, Y.; Zheng, X.; Wei, F.; Lin, Q.; Lin, F.; Xu, Y. Molecular structure design of polybenzoxazines with low surface energy and low modulus for marine antifouling application. Prog. Org. Coat. 2024, 187, 108165. [Google Scholar] [CrossRef]
- Zheng, L.; Lin, Y.; Wang, D.; Chen, J.; Yang, K.; Zheng, B.; Bai, W.; Jian, R.; Xu, Y. Facile one-pot synthesis of silver nanoparticles encapsulated in natural polymeric urushiol for marine antifouling. RSC Adv. 2020, 10, 13936–13943. [Google Scholar] [CrossRef] [PubMed]
- Xu, H.; Lu, Z.; Zhang, G. Synthesis and properties of thermosetting resin based on urushiol. RSC Adv. 2012, 2, 2768–2772. [Google Scholar] [CrossRef]
- ASTM D1141-1998 (2013); Standard Practice for the Preparation of Substitute Ocean Water. ASTM International: West Conshohocken, PA, USA, 2013.
- ASTM B499-2009 (2014); Standard Test Method for Measurement of Coating Thicknesses by the Magnetic Method: Nonmagnetic Coatings on Magnetic Basis Metals. ASTM International: West Conshohocken, PA, USA, 2014.
- Chen, J.; Zhao, J.; Lin, F.; Zheng, X.; Jian, R.; Lin, Y.; Wei, F.; Lin, Q.; Bai, W.; Xu, Y. Polymerized tung oil toughened urushiol-based benzoxazine copper polymer coatings with excellent antifouling performances. Prog. Org. Coat. 2023, 177, 107411. [Google Scholar] [CrossRef]
- Xia, J.; Xu, Y.; Lin, J.; Hu, B. UV-induced polymerization of urushiol without photoinitiator. Prog. Org. Coat. 2008, 61, 7–10. [Google Scholar] [CrossRef]
- Kemp, M.M.; Kumar, A.; Clement, D.; Ajayan, P.; Mousa, S.; Linhardt, R.J. Hyaluronan- and heparin-reduced silver nanoparticles with antimicrobial properties. Nanomedicine 2009, 4, 421–429. [Google Scholar] [CrossRef]
- Ramstedt, M.; Franklyn, P. Difficulties in determining valence for Ag0 nanoparticles using XPS—Characterization of nanoparticles inside poly (3-sulphopropyl methacrylate) brushes. Surf. Interface Anal. 2010, 42, 855–858. [Google Scholar] [CrossRef]
- Prieto, P.; Nistor, V.; Nouneh, K.; Oyama, M.; Abd-Lefdil, M.; Díaz, R. XPS study of silver, nickel and bimetallic silver–nickel nanoparticles prepared by seed-mediated growth. Appl. Surf. Sci. 2012, 258, 8807–8813. [Google Scholar] [CrossRef]
- Wang, A.; Yin, H.; Ren, M.; Liu, Y.; Jiang, T. Synergistic effect of silver seeds and organic modifiers on the morphology evolution mechanism of silver nanoparticles. Appl. Surf. Sci. 2008, 254, 6527–6536. [Google Scholar] [CrossRef]
- Chen, L.; Zheng, L.; Lv, Y.; Liu, H.; Wang, G.; Ren, N.; Liu, D.; Wang, J.; Boughton, R.I. Chemical assembly of silver nanoparticles on stainless steel for antimicrobial applications. Surf. Coat. Technol. 2010, 204, 3871–3875. [Google Scholar] [CrossRef]
- Inbakandan, D.; Sivaleela, G.; Magesh Peter, D.; Kiurbagaran, R.; Venkatesan, R.; Ajmal Khan, S. Marine sponge extract assisted biosynthesis of silver nanoparticles. Mater. Lett. 2012, 87, 66–68. [Google Scholar] [CrossRef]
- Vidhu, V.K.; Philip, D. Catalytic degradation of organic dyes using biosynthesized silver nanoparticles. Micron 2014, 56, 54–62. [Google Scholar] [CrossRef] [PubMed]
- Patil, M.P.; Piad, L.L.A.; Bayaraa, E.; Subedi, P.; Tarte, N.H.; Kim, G.-D. Doxycycline hyclate mediated silver–silver chloride nanoparticles and their antibacterial activity. J. Nanostruct. Chem. 2019, 9, 53–60. [Google Scholar] [CrossRef]
- Bhaduri, G.A.; Little, R.; Khomane, R.B.; Lokhande, S.U.; Kulkarni, B.D.; Mendis, B.G.; Šiller, L. Green synthesis of silver nanoparticles using sunlight. J. Photochem. Photobiol. A 2013, 258, 1–9. [Google Scholar] [CrossRef]
- Lu, P.; Kim, D.-W.; Park, D.-W. Silver nanoparticle-loaded filter paper: Innovative assembly method by nonthermal plasma and facile application for the reduction of methylene blue. Surf. Coat. Technol. 2019, 366, 7–14. [Google Scholar] [CrossRef]
- Romaniuk, J.A.; Cegelski, L. Bacterial cell wall composition and the influence of antibiotics by cell-wall and whole-cell NMR. Philos. Trans. R. Soc. B 2015, 370, 20150024. [Google Scholar] [CrossRef]
- Huang, K.C.; Mukhopadhyay, R.; Wen, B.; Gitai, Z.; Wingreen, N.S. Cell shape and cell-wall organization in Gram-negative bacteria. Proc. Natl. Acad. Sci. USA 2008, 105, 19282–19287. [Google Scholar] [CrossRef] [PubMed]
- Singh, R.; Shedbalkar, U.U.; Wadhwani, S.A.; Chopade, B.A. Bacteriagenic silver nanoparticles: Synthesis, mechanism, and applications. Appl. Microbiol. Biotechnol. 2015, 99, 4579–4593. [Google Scholar] [CrossRef] [PubMed]
- Zhang, C.; Hu, Z.; Deng, B. Silver nanoparticles in aquatic environments: Physiochemical behavior and antimicrobial mechanisms. Water Res. 2016, 88, 403–427. [Google Scholar] [CrossRef] [PubMed]
- Backx, B.P.; Dos Santos, M.S.; Dos Santos, O.A.L.; Filho, S.A. The Role of Biosynthesized Silver Nanoparticles in Antimicrobial Mechanisms. Curr. Pharm. Biotechnol. 2021, 22, 762–772. [Google Scholar] [CrossRef] [PubMed]
- Moreno-Garrido, I.; Perez, S.; Blasco, J. Toxicity of silver and gold nanoparticles on marine microalgae. Mar. Environ. Res. 2015, 111, 60–73. [Google Scholar] [CrossRef] [PubMed]
- Sendra, M.; Yeste, M.P.; Gatica, J.M.; Moreno-Garrido, I.; Blasco, J. Direct and indirect effects of silver nanoparticles on freshwater and marine microalgae (Chlamydomonas reinhardtii and Phaeodactylum tricornutum). Chemosphere 2017, 179, 279–289. [Google Scholar] [CrossRef]
- Johari, S.A.; Sarkheil, M.; Behzadi Tayemeh, M.; Veisi, S. Influence of salinity on the toxicity of silver nanoparticles (AgNPs) and silver nitrate (AgNO3) in halophilic microalgae, Dunaliella salina. Chemosphere 2018, 209, 156–162. [Google Scholar] [CrossRef]

| Samples | UOB (g) | AgNO3 (g) | Corresponding Polymer Nomenclature |
|---|---|---|---|
| UOB | 10 | 0 | UOHP |
| UOB-0.05%AgNPs | 9.995 | 0.005 | UOHP-0.05%AgNPs |
| UOB-0.1% AgNPs | 9.99 | 0.01 | UOHP-0.1% AgNPs |
| UOB-0.5% AgNPs | 9.95 | 0.05 | UOHP-0.5% AgNPs |
| UOB-1% AgNPs | 9.90 | 0.1 | UOHP-1% AgNPs |
| Samples | T5% (°C) | Tmax (°C) | Residue at 600 °C (%) |
|---|---|---|---|
| UOHP | 253.8 | 435.6 | 20.9 |
| UOHP-0.05%AgNPs | 253.7 | 432.8 | 23.7 |
| UOHP-0.1% AgNPs | 252.0 | 435.8 | 25.6 |
| UOHP-0.5% AgNPs | 250.8 | 436.2 | 31.0 |
| UOHP-1% AgNPs | 254.8 | 424.7 | 36.1 |
Disclaimer/Publisher’s Note: The statements, opinions and data contained in all publications are solely those of the individual author(s) and contributor(s) and not of MDPI and/or the editor(s). MDPI and/or the editor(s) disclaim responsibility for any injury to people or property resulting from any ideas, methods, instructions or products referred to in the content. |
© 2024 by the authors. Licensee MDPI, Basel, Switzerland. This article is an open access article distributed under the terms and conditions of the Creative Commons Attribution (CC BY) license (https://creativecommons.org/licenses/by/4.0/).
Share and Cite
Chen, J.; Zheng, X.; Jian, R.; Bai, W.; Zheng, G.; Xie, Z.; Lin, Q.; Lin, F.; Xu, Y. In Situ Reduction of Silver Nanoparticles/Urushiol-Based Polybenzoxazine Composite Coatings with Enhanced Antimicrobial and Antifouling Performances. Polymers 2024, 16, 1167. https://doi.org/10.3390/polym16081167
Chen J, Zheng X, Jian R, Bai W, Zheng G, Xie Z, Lin Q, Lin F, Xu Y. In Situ Reduction of Silver Nanoparticles/Urushiol-Based Polybenzoxazine Composite Coatings with Enhanced Antimicrobial and Antifouling Performances. Polymers. 2024; 16(8):1167. https://doi.org/10.3390/polym16081167
Chicago/Turabian StyleChen, Jipeng, Xiaoxiao Zheng, Rongkun Jian, Weibin Bai, Guocai Zheng, Zhipeng Xie, Qi Lin, Fengcai Lin, and Yanlian Xu. 2024. "In Situ Reduction of Silver Nanoparticles/Urushiol-Based Polybenzoxazine Composite Coatings with Enhanced Antimicrobial and Antifouling Performances" Polymers 16, no. 8: 1167. https://doi.org/10.3390/polym16081167
APA StyleChen, J., Zheng, X., Jian, R., Bai, W., Zheng, G., Xie, Z., Lin, Q., Lin, F., & Xu, Y. (2024). In Situ Reduction of Silver Nanoparticles/Urushiol-Based Polybenzoxazine Composite Coatings with Enhanced Antimicrobial and Antifouling Performances. Polymers, 16(8), 1167. https://doi.org/10.3390/polym16081167








